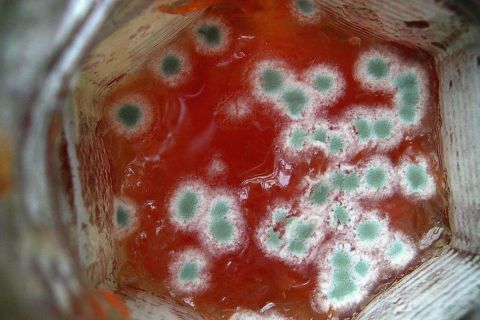

계란은 오랜 기간 동안 세계 각지의 주방에서 핵심 식품으로 자리매김한 이유가 있습니다. 계란은 필수 영양소로 가득 차 있고 저렴한 가격, 다양하며 쉽게 조리할 수 있는 특성 등이 있는 훌륭한 식재료입니다.
이 글에서는 계란의 다양한 효능 및 영양성분에 대해 자세히 알아보고 계란으로 만들 수 있는 다양한 음식을 살펴보겠습니다.

계란의 효능 및 주요 영양 성분
1. 고함량의 단백질
계란은 높은 품질의 단백질 함유량으로 유명합니다. 대란 1구는 약 6g의 단백질을 포함하고 있어 이일 권장 단백질 섭취량을 충족시키기에 좋습니다. 계란의 단백질에는 근육 회복 및 성장에 중요한 모든 필수 아미노산이 포함되어 있는 완전식품입니다.
2. 풍부한 비타민 및 미네랄
계란은 필수 비타민 및 미네랄의 보물창고입니다. 특히 신경 기능과 적혈구 형성에 필수적인 비타민 B12의 함량이 높습니다. 게다가 계란은 뼈 건강에 필수적인 비타민 D의 좋은 원천이며, 강력한 항산화제로 작용하는 셀레늄과 같은 미네랄도 포함하고 있습니다.
3. 건강한 지방
예전에 계란 노른자의 지방을 먹으면 콜레스테롤 수치가 높아져 몸에 해롭다는 내용이 있었으나 이러한 내용은 오해인 것으로 알려졌습니다. 계란의 지방은 주로 불포화 지방이며 심장건강에 도움이 되며, 특히 계란에 함유된 오메가 3 지방산은 심혈관 건강에도 좋은 효과가 있는 것으로 알려졌습니다.
비오틴 결핍증상 탈모, 비오틴이 많이 든 음식
한국의 탈모 환자 수는 약 1000만 명으로 5명 중 1명꼴로 탈모를 앓고 있다고 합니다, 슬프게도 저도 탈모 환자인데요 외가 쪽의 탈모 유전자를 물려받아서 관리를 하더라도 조금씩 머리가 빠지는
toptennam2.tistory.com
계란으로 만들 수 있는 음식
1. 오믈렛
오믈렛은 다양한 야채, 허브 및 심지어 저지방 단백질과 사용자 정의할 수 있는 빠른 영양 식사입니다. 단백질과 건강한 지방의 완벽한 균형으로 아침이나 브런치에 이상적인 선택지입니다.
재료: 계란, 야채 (양파, 당근, 토마토), 치즈 (선택 사항), 소금, 후추 및 올리브 오일.
2. 아보카도 토스트에 포장된 포슷한 계란
트렌디한 인스타그램에서도 인기 있는 아보카도 토스트는 아보카도의 부드러움과 포슷한 계란의 단백질을 즐길 수 있는 음식입니다. 맛있고 영양이 풍부해 아침식사나 점심에 가볍게 먹을 수 있습니다.
재료: 계란, 통곡물 빵, 익은 아보카도, 레몬주스, 소금 및 후추.
3. 계란 샐러드 상추 랩
저탄수화물 식단으로 계란 샐러드를 만들어 신선한 상추 잎으로 싸 먹을 수 있습니다. 이 상쾌하고 만족스러운 요리는 준비가 쉽고 녹색채소를 섭취하는 좋은 방법 중 하나입니다.
재료: 계란, 마요네즈, 겨자, 셀러리, 소금, 후추 및 상추 잎.
4. 야채 후리타타
후리타 타는 나머지 야채를 소진하는 환상적인 방법입니다. 냉장고에서 더욱더 풍부한 단백질 식사를 만들 수 있으며, 뜨거울 때나 차가울 때나 모두 맛있게 즐길 수 있습니다.
재료: 계란, 혼합 야채 (호박, 버섯, 양파), 치즈, 소금 및 후추.
계란 섭취 시 주의해야 할 점
계란 섭취 시에 살모넬라균을 조심하라는 말 많이 들어보셨을 겁니다. 살모넬라균은 식중독의 원인 을로 오염의 위험을 줄이기 위해 다음과 같은 주의사항을 지켜야 합니다.
- 냉장고에 계란 보관: 계란을 냉장고의 선반에 보관하여 신선도를 유지하고 세균 증식의 위험을 줄입니다.
- 신선도 확인: 계란을 사용하기 전에 균열이나 이상한 냄새가 없는지 확인하십시오. 신선한 계란은 안전성과 맛 모두에 중요합니다.
- 철저한 익힘: 계란이 흰자와 노른자가 모두 굳어질 때까지 요리하십시오. 이렇게 하면 잠재적인 세균이 죽어 안전하게 섭취할 수 있게 됩니다.
- 교차 오염 피하기: 원유알을 다룬 후에는 손이나 식기류의 표면을 철저히 세척하여 세균 증식을 방지합니다.

계란 관련 결론
요약하면 계란은 맛뿐만 영양도 풍부한 완전식품으로서 건강을 위해 섭취할 수 있는 식품입니다. 고함량의 단백질 및 필수 비타민 및 미네랄까지 계란만으로도 많은 영양분을 보충할 수 있습니다.
또한 계란을 오믈렛, 아보카도 토스트, 계란 샐러드 랩, 야채 후리타타와 같은 다양한 요리에 계란을 넣어 맛있게 섭취하며 건강을 챙길 수도 있습니다. 이러한 계란은 몸에 해로운 성분이 없으니 충분히 섭취하도록 합시다.
'건강 > 식품 건강' 카테고리의 다른 글
| 배는 껍질채 먹는게 더 좋다? 껍질채 먹으면 안되는 과일은? (0) | 2023.12.26 |
|---|---|
| 눈 밑 지방의 원인과 해결방법, 눈 밑 지방 재배치란? (0) | 2023.12.25 |
| 간과 피로에 좋은 음식, 음주 후 숙취 줄이는 방법 (0) | 2023.12.23 |
| 관상동맥질환, 동맥경화에 치명적인 콜레스트롤이란? (0) | 2023.12.23 |
| 사골국물 먹으면 뼈 튼튼해진다는 속설, 진짜일까? (0) | 2023.12.23 |